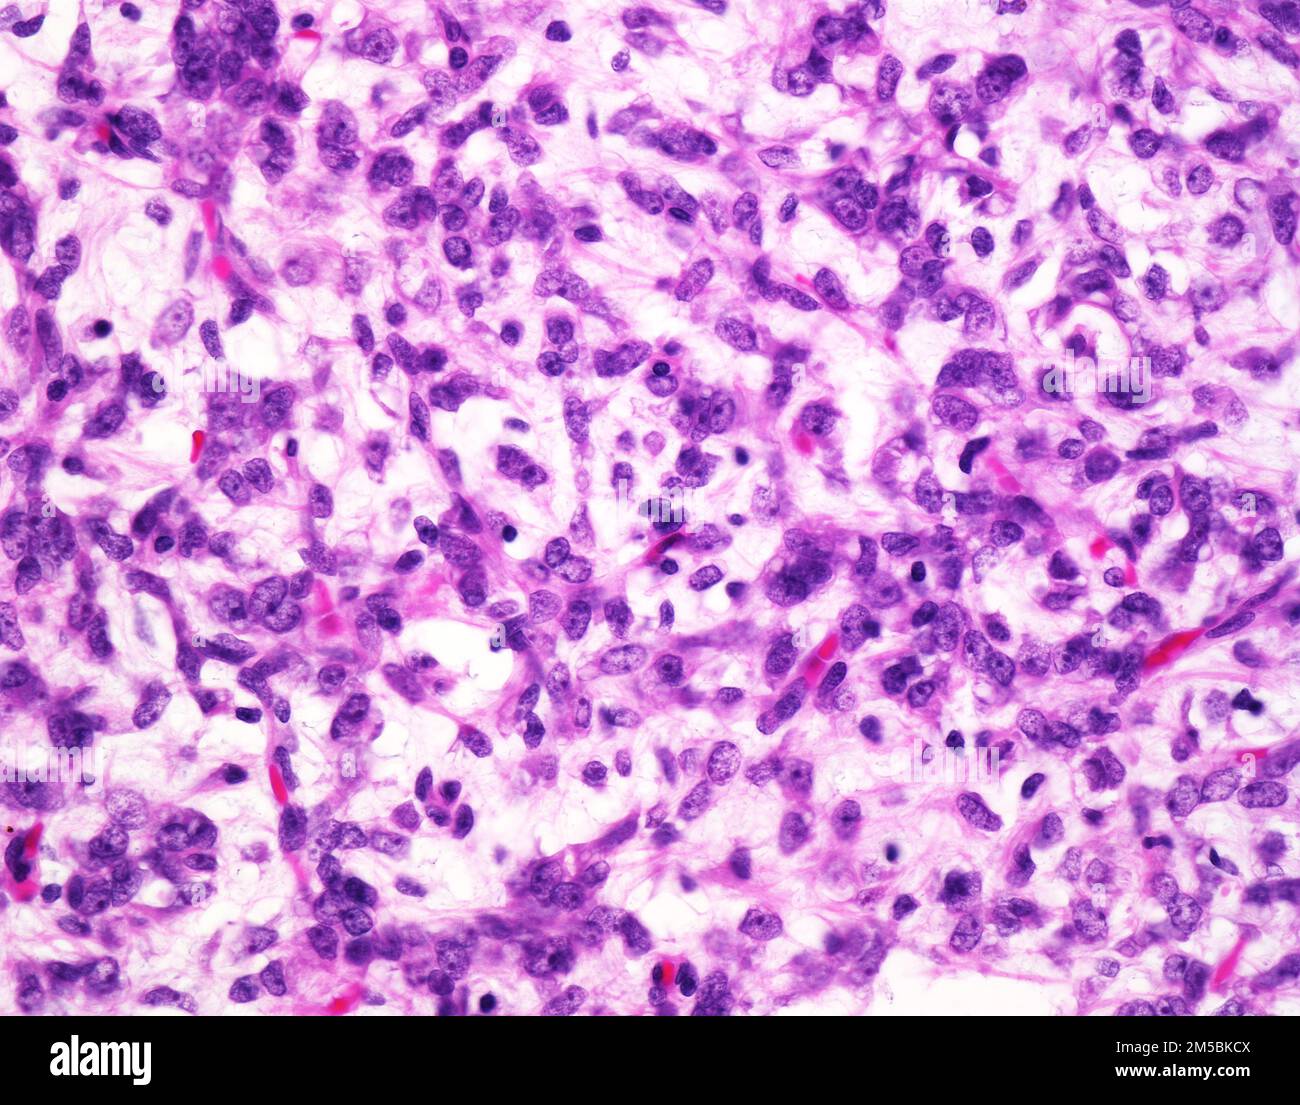

Фото Липосаркомы Мягких
Фото Липосаркомы Мягких 115 фото
Рубли Фото Для Печати
Худые Невесты Фото
Смешные Картинки До Слез Обезьян
Фото Войны Моряки
Астильба Садовая Фото
Узкая Спальня Дизайн Фото Хрущевка
Вертолет Ми 24 Технические Характеристики Фото
Большие Сиськи В Лифчике Домашнее Фото
Поздравительные Картинки 1 Сентября
Создать Поющее Фото